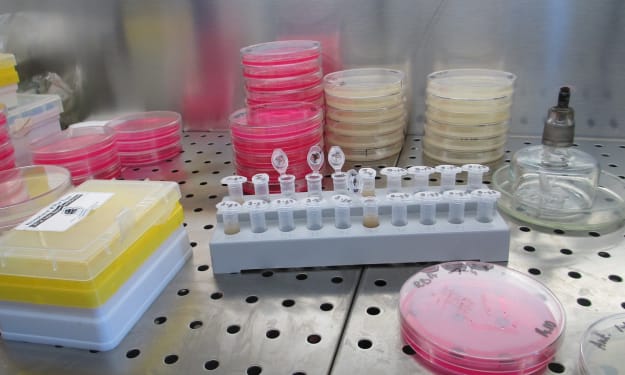

Colleen Millsteed
Joined May 2021
1348 stories
Bio
My first love is poetry — it’s like a desperate need to write, to free up space in my mind, to escape the constant noise in my head. Most of the time the poems write themselves — I’m just the conduit holding the metaphorical pen.
Stories (1348)
Filter by community
By The Skin Of Her Teeth
Oh no, the destruction of the laboratory’s reputation is on the line this time! Sky knew she needed to fix her mistake and fix it quick. Her skin’s beginning to show signs of the rash from that deadly virus she’d accidentally injected herself with.
By Colleen Millsteed 2 years ago in Fiction